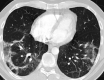

Organizing pneumonia following Covid19 pneumonia
- PMID: 33861398
- PMCID: PMC8050821
- DOI: 10.1007/s00508-021-01852-9
Organizing pneumonia following Covid19 pneumonia
Abstract
The potential mid-term and long-term consequences after severe acute respiratory syndrome coronavirus 2 (SARS-CoV-2) infections are as yet unknown. This is the first report of bronchoscopically verified organizing pneumonia as a complication of coronavirus disease 2019 (Covid19). It caused persisting dyspnea, impaired pulmonary function, and radiological abnormalities over 5 weeks after onset of symptoms. While organizing pneumonia frequently requires treatment with systemic corticosteroids, in this case it resolved spontaneously without treatment after 6 weeks. Healthcare professionals should consider organizing pneumonia in patients with persisting respiratory symptoms after Covid19.
Keywords: Fibrosis; Inflammatory lung disease; Interstitial lung disease; Long Covid; Pulmonary infection.
© 2021. The Author(s).
Conflict of interest statement
G.-C. Funk, C. Nell, W. Pokieser, B. Thaler, G. Rainer and A. Valipour report no conflict of interest and have read and approved the submission.
Figures

References
MeSH terms
LinkOut - more resources
Full Text Sources
Other Literature Sources
Medical
Miscellaneous